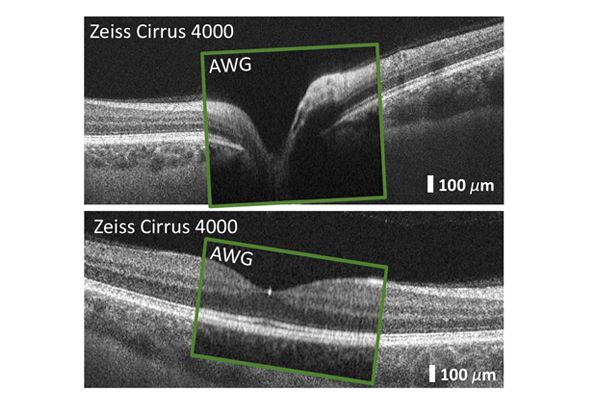

(Vienna, 20 January 2021) The first in vivo images of the human retina have been generated with a miniaturised spectrometer for Optical Coherence Tomography at MedUni Vienna’s Center for Medical Physics and Biomedical Engineering.
This represents one step closer towards realising the goal of a miniaturised Optical Coherence Tomograph (OCT) built into a photonic chip. Working with colleagues from an Austrian consortium (AIT Austrian Institute of Technology GmbH, ams AG and FH Vorarlberg), Elisabet A. Rank et al. from MedUni Vienna's Center for Medical Physics and Biomedical Engineering have shown that a miniaturised spectrometer (Arrayed Waveguide Grating or AWG), which is normally used to separate different wavelength channels in an optical communication system, could replace conventional spectrometers in an OCT system.
Several designs of silicon nitride AWGs with 256 channels in the near infrared range were produced and then tested in an OCT system that was able to take in vivo tomograms and angiograms of the human retina of a quality comparable to that of a commercially used system.
The next steps in the OCT-on-a-chip research will focus on researching the use of multi-mode interference structures, integrated photodiodes and compact light sources.
The results were recently published in the Nature publication Light: Science and Applications (impact factor 14.5): https://rdcu.be/cc5i0
OCT – developed by MedUni Vienna
Optical Coherence Tomography (OCT) is a high-resolution live imaging technique that can be used for early detection of retinal diseases, such as age-related macular degeneration, diabetes-related conditions, glaucoma or vascular occlusions. Optical Coherence Tomography works in a similar way to ultrasound scanning but uses light and is contact-free, producing high-resolution cross-sectional images of biological tissue. OCT was initiated and refined at MedUni Vienna, in the Center for Medical Physics and Biomedical Engineering, and underwent continuous clinically testing at the Department of Ophthalmology and Optometrics.